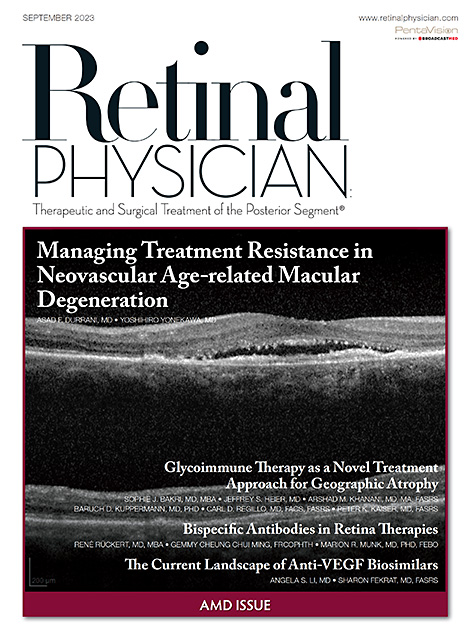

Trending Topics
-

TOPOGRAPHY & TOMOGRAPHY
An exploration of technological innovation and its influence on contact lens design and fitting. Learn More
-

PHARMACEUTICALLY ENHANCING SPECIALTY LENS OUTCOMES
How therapeutic medicines can help improve specialty lens outcomes. Learn More
-

IFSLR 2023 RECAP
Sessions covered new instrumentation and technology, therapeutics and solutions, and scleral lenses in special populations. Learn More
-

CONTACT LENS PRACTICE PEARLS
AI Technology and the Contact Lens Practice Learn More
-

ORTHOKERATOLOGY TODAY
When Optical Biometry Saves the Day Learn More
-

-

-

-

-

-

Establishing efficiency
Massachusetts Eye Research & Surgery Institution’s retina staff doesn’t waste time, thanks to these eight action steps. Learn More
-

Building the ideal OCT imager
Develop these skills to acquire clear, accurate images. Learn More
-

Career opportunities in ophthalmic photography
Experience gained in this important role can open a variety of career paths. Learn More
-

MAXIMIZING EFFICIENCY IN A HIGH-VOLUME ASC
How implementing advanced technologies and streamlining patient flow can boost productivity Learn More
-

THE CASE FOR STANDALONE MIGS
Micro-invasive glaucoma surgery benefits patients too much to wait until cataract surgery. Learn More
-

TURNING TIME INTO REIMBURSEMENT
Part one of this two part series highlights how to be more effective and efficient in a challenging economic environment. Learn More
-

ADDING A NEW ASSOCIATE
Once you determine it’s the right time to bring a new doctor to your practice, make the transition seamless. Learn More
-

CODING & REIMBURSEMENT
THE ANSWER FOR DISCARDED DRUG Learn More
-

GUEST EDITORIAL
STRIVING FOR EXCELLENCE Learn More
-
OD to OD
Advice for your younger self Learn More
-
Satisfy the Needs of Plano Presbyopes
How to prepare patients for presbyopia and explain the treatment options available Learn More
-
Creating Happier Hyperopes
How to achieve patient satisfaction with this patient population Learn More
-
Collaborate on Concussion Management
Why ODs are needed, the treatment approaches, and how to create referral relationships Learn More
-
-

Managing Treatment Resistance in Neovascular Age-related Macular Degeneration
Novel therapies are on the horizon. Learn More
-

Glycoimmune Therapy as a Novel Treatment Approach for Geographic Atrophy
A dual-mechanism therapy is in development. Learn More
-

Bispecific Antibodies in Retina Therapies
More targets could mean better efficacy. Learn More
-

The Current Landscape of Anti-VEGF Biosimilars
New products may reduce the cost of treating retinal diseases. Learn More
-
Systemic Medications and Lifestyle Factors in AMD
Studies are under way to determine methods to prevent or delay progression. Learn More
